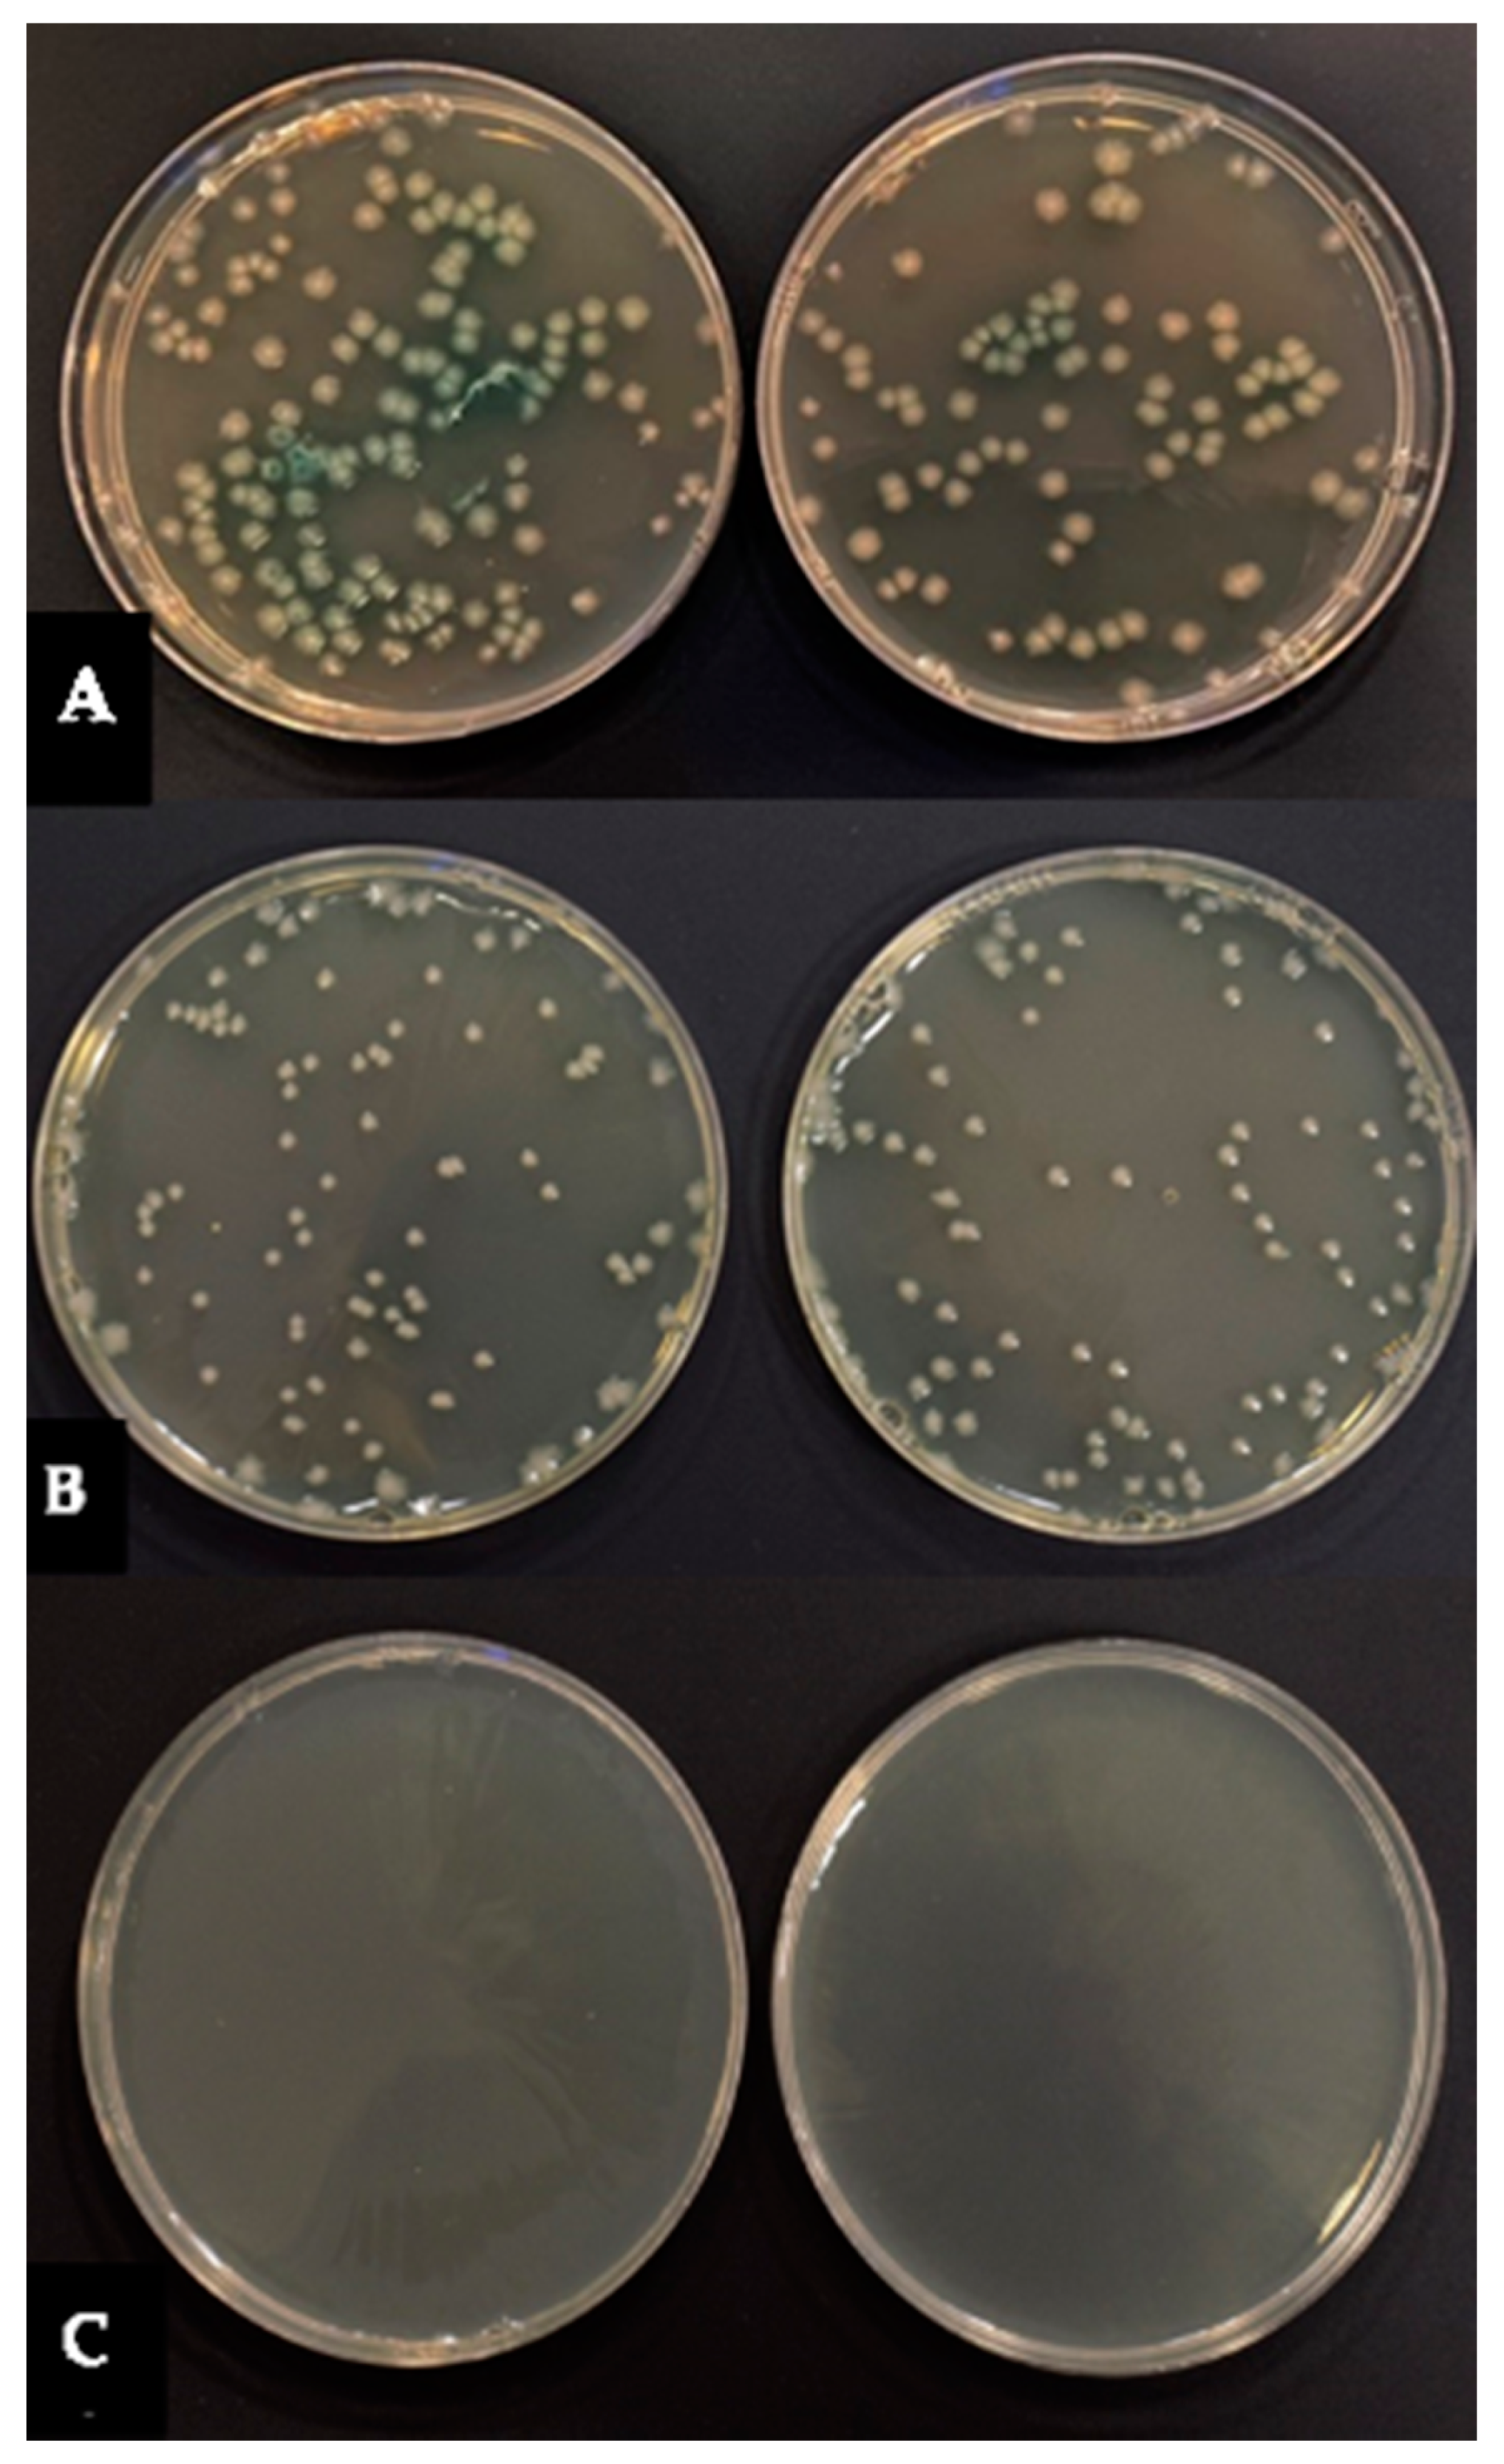
Applsci 12 03707 g002 550

Promising Photocytotoxicity of Water-Soluble Phtalocyanine against Planktonic and Biofilm Pseudomonas aeruginosa Isolates from Lower Respiratory Tract and Chronic Wounds
Abstract
:1. Introduction
2. Materials and Methods
2.1. Photosensitizer and Light Source
2.2. Bacterial Strains
2.3. Antimicrobial Susceptibility Testing
- Sensitivity to antimicrobials:
- Detecting carbapenemases in P. aeruginosa strains:
2.4. Quantitative Assessment of Biofilm Formation
2.5. Effect of PACT on Bacterial Planktonic Form
- photodynamic inactivation—R1 = Log L(-)Ps(-)—Log L(+)Ps(+);
- dark toxicity—R2 = Log L(-)Ps(-)—Log L(-)Ps(+);
- L(-)Ps(-)—no irradiation, no Pc+ (negative control)
- L(-)Ps(+)—no irradiation, Pc+ (dark control)
- L(+)Ps(+)—irradiation, Pc+
2.6. Effect of PACT on Biofilm
2.7. Statistical Analysis
3. Results
3.1. Resistance Patterns and Ability to Form Biofilm of P. aeruginosa Strains
3.2. Photoinactivation of P. aeruginosa by PACT
3.3. Effect of PACT on P. aeruginosa Biofilm
4. Discussion
5. Conclusions
Author Contributions
Funding
Institutional Review Board Statement
Informed Consent Statement
Data Availability Statement
Acknowledgments
Conflicts of Interest
References
- Brugha, R.E.; Davies, J.C. Pseudomonas aeruginosa in cystic fibrosis: Pathogenesis and new treatments. Br. J. Hosp. Med. 2013, 72, 614–619. [Google Scholar] [CrossRef] [PubMed]
- Cattaneo, C.; Antoniazzi, F.; Casari, S.; Ravizzola, G.; Gelmi, M.; Pagani, C.; D’Adda, M.; Morello, E.; Re, A.; Borlenghi, E.; et al. P. aeruginosa bloodstream infections among hematological patients: An old or new question? Ann. Hematol. 2012, 91, 1299–1304. [Google Scholar] [CrossRef] [PubMed]
- Church, D.; Elsayed, S.; Reid, O.; Winston, B.; Lindsay, R. Burn Wound Infections. Clin. Microbiol. Rev. 2006, 19, 403–434. [Google Scholar] [CrossRef] [PubMed] [Green Version]
- Gaspar, M.C.; Couet, W.; Olivier, J.C.; Pais, A.A.; Sousa, J.J. Pseudomonas aeruginosa infection in cystic fibrosis lung disease and new perspectives of treatment: A review. Eur. J. Clin. Microbiol. Infect. Dis. 2013, 32, 1231–1252. [Google Scholar] [CrossRef]
- Ruhnke, M.; Arnold, R.; Gastmeier, P. Infection control issues in patients with haematological malignancies in the era of multidrug-resistant bacteria. Lancet Oncol. 2014, 5, e606–e619. [Google Scholar] [CrossRef]
- Azzopardi, E.A.; Azzopardi, E.; Camilleri, L.; Villapalos, J.; Dean, E.; Boyce, D.E.; Dziewulski, P.; Dickson, W.A.; Whitaker, I.S. Gram Negative Wound Infection in Hospitalised Adult Burn Patients-Systematic Review and Metanalysis. PLoS ONE 2014, 9, e95042. [Google Scholar] [CrossRef] [Green Version]
- Hilker, R.; Munder, A.; Klockgether, J.; Losada, P.M.; Chouvarine, P.; Cramer, N.; Davenport, C.F.; Dethlefsen, S.; Fischer, S.; Peng, H.; et al. Interclonal gradient of virulence in the Pseudomonas aeruginosa pangenome from disease and environment. Environ. Microbiol. 2015, 17, 29–46. [Google Scholar] [CrossRef]
- Lusignani, L.S.; Blacky, A.; Starzengruber, P.; Diab-Elschahawi, M.; Wrba, T.; Presterl, E. A national point prevalence study on healthcare-associated infections and antimicrobial use in Austria. Wien. Klin. Wochenschr. 2016, 128, 89–94. [Google Scholar] [CrossRef]
- Sader, H.S.; Castanheira, M.; Duncan, L.R.; Flamm, R.K. Antimicrobial Susceptibility of Enterobacteriaceae and Pseudomonas aeruginosa Isolates from United States Medical Centers Stratified by Infection Type: Results from the International Network for Optimal Resistance Monitoring (INFORM) Surveillance Program, 2015–2016. Diagn. Micr. Infec. Dis. 2018, 92, 69–74. [Google Scholar]
- Recio, R.; Villa, J.; Viedma, E.; Orellana, M.A.; Lora-Tamayo, J.; Chaves, F. Bacteraemia due to extensively drug-resistant Pseudomonas aeruginosa sequence type 235 high-risk clone: Facing the perfect storm. Int. J. Antimicrob. Agents 2018, 52, 172–179. [Google Scholar] [CrossRef]
- Chatterjee, M.; Anju, C.P.; Biswas, L.; Anil Kumar, V.; Gopi Mohan, C.; Biswas, R. Antibiotic resistance in Pseudomonas aeruginosa and alternative therapeutic options. Int. J. Med. Microbiol. 2016, 306, 48–58. [Google Scholar] [CrossRef] [PubMed]
- Potron, A.; Poirel, L.; Nordmann, P. Emerging broad-spectrum resistance in Pseudomonas aeruginosa and Acinetobacter baumannii: Mechanisms and epidemiology. Int. J. Antimicrob. Agents 2015, 45, 568–585. [Google Scholar] [CrossRef] [PubMed] [Green Version]
- Husain, F.M.; Qais, F.A.; Ahmad, I.; Hakeem, M.J.; Baig, M.H.; Khan, J.M.; Al-Shabib, N.A. Biosynthesized zinc oxide nanoparticles disrupt established biofilms of pathogenic bacteria. Appl. Sci. 2022, 12, 710. [Google Scholar] [CrossRef]
- Mulcahy, L.R.; Isabella, V.M.; Lewis, K. Pseudomonas aeruginosa biofilms in disease. Microb. Ecol. 2014, 68, 1–12. [Google Scholar] [CrossRef] [Green Version]
- Pang, Z.; Raudonis, R.; Glick, B.R.; Lin, T.J.; Cheng, Z. Antibiotic resistance in Pseudomonas aeruginosa: Mechanisms and alternative therapeutic strategies. Biotechnol. Adv. 2019, 37, 177–192. [Google Scholar] [CrossRef]
- Poonsuk, K.; Tribuddharat, C.; Chuanchuen, R. Simultaneous overexpression of multidrug efflux pumps in Pseudomonas aeruginosa non-cystic fibrosis clinical isolates. Can. J. Microbiol. 2014, 60, 437–443. [Google Scholar] [CrossRef]
- Hamblin, M.R. Antimicrobial photodynamic inactivation: A bright new technique to kill resistant microbes. Curr. Opin. Microbiol. 2016, 33, 67–73. [Google Scholar] [CrossRef] [Green Version]
- Mahmoudi, H.; Bahador, A.; Pourhajibagher, M.; Alikhani, M.H. Antimicrobial Photodynamic Therapy: An Effective Alternative Approach to Control Bacterial Infections. J. Lasers. Med. Sci. 2018, 9, 154. [Google Scholar] [CrossRef] [Green Version]
- Awad, M.M.; Tovmasyan, A.; Craik, J.D.; Batinic-Haberle, I.; Benov, L.T. Important cellular targets for antimicrobial photodynamic therapy. Appl. Microbiol. Biotechnol. 2016, 100, 7679–7688. [Google Scholar] [CrossRef]
- Ragàs, X.; He, X.; Agut, M.; Roxo-Rosa, M.; Gonsalves, A.R.; Serra, A.C.; Nonell, S. Singlet Oxygen in Antimicrobial Photodynamic Therapy: Photosensitizer-Dependent Production and Decay in E. coli. Molecules 2013, 18, 2712–2725. [Google Scholar] [CrossRef] [Green Version]
- Cieplik, F.; Dongmei Deng, D.; Crielaard, W.; Buchalla, W.; Hellwig, E.; Al-Ahmad, A.; Maisch, T. Antimicrobial photodynamic therapy—What we know and what we don’t. Crit. Rev. Microbiol. 2018, 44, 571–589. [Google Scholar] [CrossRef] [PubMed] [Green Version]
- Liu, Y.; Qin, R.; Zaat, S.A.J.; Breukink, E.; Heger, M. Antibacterial photodynamic therapy: Overview of a promising approach to fight antibiotic-resistant bacterial infections. J. Clinic. Transl. Res. 2015, 1, 140–167. [Google Scholar]
- Skupin-Mrugalska, P.; Koczorowski, T.; Szczolko, W.; Dlugaszewska, J.; Teubert, A.; Piotrowska-Kempisty, H.; Goslinski, T.; Sobotta, L. Cationic porphyrazines with morpholinoethyl substituents—Syntheses, optical properties, and photocytotoxicities. Dye. Pigment. 2022, 197, 109937. [Google Scholar] [CrossRef]
- Benov, L. Photodynamic Therapy: Current Status and Future Directions. Med. Princ. Pract. 2015, 24 (Suppl. 1), 14–28. [Google Scholar] [CrossRef] [PubMed]
- Abrahamse, H.; Hamblin, M.R. New photosensitizers for photodynamic therapy. Biochem. J. 2016, 473, 347–364. [Google Scholar] [CrossRef] [Green Version]
- Ormond, A.B.; Freeman, H.S. Dye Sensitizers for Photodynamic Therapy. Materials 2013, 6, 817–840. [Google Scholar] [CrossRef] [Green Version]
- Donzello, M.P.; Ercolani, D.; Gaberkorn, A.A.; Kudrik, E.V.; Meneghetti, M.; Marcolongo, G.; Rizzoli, C.; Stuzhin, P.A. Synthesis, X-ray crystal structure, UV/Visible linear and nonlinear (optical limiting) spectral properties of symmetrical and unsymmetrical porphyrazines with annulated 1,2,5-thiadiazole and 1,4-diamyloxybenzene moieties. Chem. Eur. J. 2003, 9, 4009–4024. [Google Scholar] [CrossRef]
- Yano, S.; Hirohara, S.; Obata, M.; Hagiya, Y.; Ichiro Ogura, S.; Ikeda, A.; Kataoka, H.; Tanaka, M.; Joh, T. Current states and future views in photodynamic therapy. J. Photochem. Photobiol. 2011, 12, 46–67. [Google Scholar] [CrossRef]
- Dlugaszewska, J.; Szczolko, W.; Koczorowski, T.; Skupin-Mrugalska, P.; Teubert, A.; Konopka, K.; Kucinska, M.; Murias, M.; Düzgüneş, N.; Mielcarek, J.; et al. Antimicrobial and anticancer photodynamic activity of a phthalocyanine photosensitizer with N-methyl morpholiniumethoxy substituents in nonperipheral positions. J. Inorg. Biochem. 2017, 172, 67–79. [Google Scholar] [CrossRef]
- Dur, E.; Bulut, M. Derivatizable novel β-tetra 7-oxycoumarin-3-carboxylate substituted metallophthalocyanines: Synthesis and characterization. Polyhedron 2010, 29, 2689–2695. [Google Scholar] [CrossRef]
- Kucinska, M.; Skupin-Mrugalska, P.; Szczolko, W.; Sobotta, L.; Sciepura, M.; Tykarska, E.; Wierzchowski, M.; Teubert, A.; Fedoruk-Wyszomirska, A.; Wyszko, E.; et al. Phthalocyanine derivatives possessing 2-(morpholin-4-yl)ethoxy groups as potential agents for photodynamic therapy. J. Med. Chem. 2015, 58, 2240–2255. [Google Scholar] [CrossRef] [PubMed]
- Zhu, Y.J.; Huang, J.D.; Jiang, X.J.; Sun, J.C. Novel silicon phthalocyanines axially modified by morpholine: Synthesis, complexation with serum protein and in vitro photodynamic activity. Inorg. Chem. Commun. 2006, 9, 473–477. [Google Scholar] [CrossRef]
- Centers for Disease Control and Prevention. Antibiotic Resistance Threats in the United States; Department of Health and Human Services: Atlanta, GA, USA, 2019.
- World Health Organization. Prioritization of Pathogens to Guide Discovery, Research and Development of New Antibiotics for Drug-Resistant Bacterial Infections, Including Tuberculosis; World Health Organization: Geneva, Switzerland, 2017. [Google Scholar]
- Grinholc, M.; Szramka, B.; Kurlenda, J.; Graczyk, A.; Bielawski, K.P. Bactericidal effect of photodynamic inactivation against methicillin-resistant and methicillin-susceptible Staphylococcus aureus is strain-dependent. J. Photochem. Photobiol. 2008, 90, 57–63. [Google Scholar] [CrossRef] [PubMed]
- Lyon, J.P.; Moreira, L.M.; de Moraes, P.C.G.; dos Santos, F.V.; de Resende, M.A. Photodynamic therapy for pathogenic fungi. Mycoses 2011, 54, 265–271. [Google Scholar] [CrossRef]
- Percival, S.L.; Suleman, L.; Francolini, I.; Donelli, G. The effectiveness of photodynamic therapy on planktonic cells and biofilms and its role in wound healing. Future Microbiol. 2014, 9, 1083–1094. [Google Scholar] [CrossRef]
- EUCAST. Clinical Breakpoins—Bacteria, Version 10, European Committee on Antimicrobial Susceptibility Testing. Available online: http://www.eucast.org/clinical_breakpoints/2021 (accessed on 26 June 2021).
- UCAST. Guidelines for Detection of Resistance Mechanisms and Specific Resistance of Clinical and/or Epidemiological Importance. Version 2.0, July 2017. European Committee on Antimicrobial Susceptibility Testing. Available online: http://www.eucast.org/resistance_mechanisms/2017 (accessed on 12 February 2021).
- Stepanovic, S.; Vukovic, D.; Hola, V.; Di Bonaventura, G.; Djukić, S.; Cirković, I.; Ruzicka, F. Quantification of biofilm in microtiter plates: Overview of testing conditions and practical recommendations for assessment of biofilm production by staphylococci. APMIS 2007, 115, 891–899. [Google Scholar] [CrossRef]
- Spesia, M.B.; Rovera, M.; Durantini, E.N. Photodynamic inactivation of Escherichia coli and Streptococcus mitis by cationic zinc(II) phthalocyanines in media with blood derivatives. Eur. J. Med. Chem. 2010, 45, 2198–2205. [Google Scholar] [CrossRef]
- Segalla, A.; Borsarelli, C.D.; Braslavsky, S.E.; Spikes, J.D.; Roncucci, G.; Dei, D.; Chiti, G.; Jori, G.; Reddi, E. Photophysical, photochemical and antibacterial photosensitizing properties of a novel octacationic Zn(II)-phthalocyanine. Photochem. Photobiol. Sci. 2002, 1, 641–648. [Google Scholar] [CrossRef]
- Ruiz-González, R.; Setaro, F.; Gulías, O.; Agut, M.; Uwe Hahn, U.; Torres, T.; Nonell, S. Cationic phthalocyanine dendrimers as potential antimicrobial photosensitisers. Org. Biomol. Chem. 2018, 16, 1037. [Google Scholar] [CrossRef] [Green Version]
- Maho, T.; Binois, R.; Brulé-Morabito, F.; Demasure, M.; Douat, C.; Dozias, D.; Bocanegra, P.E.; Goard, I.; Hocqueloux, L.; Le Helloco, C.; et al. Anti-Bacterial Action of Plasma Multi-Jets in the Context of Chronic Wound Healing. Appl. Sci. 2021, 11, 9598. [Google Scholar] [CrossRef]
- Ribeiro, C.P.S.; Lourenço, L.M.O. Overview of cationic phthalocyanines for effective photoinactivation of pathogenic microorganisms. J. Photochem. Photobiol. C 2021, 48, 100422. [Google Scholar] [CrossRef]
- Mantareva, V.; Kussovski, V.; Angelov, I.; Dieter Wohrle, D.; Roumen Dimitrov, R.; Elka Popovae, E.; Dimitrov, S. Non-aggregated Ga(III)-phthalocyanines in the photodynamic inactivation of planktonic and biofilm cultures of pathogenic microorganisms. Photochem. Photobiol. Sci. 2011, 10, 91–102. [Google Scholar] [CrossRef] [PubMed]
- Ke, M.-R.; Eastel, J.M.; Ngai, K.L.K.; Cheung, Y.-Y.; Chan, P.K.S.; Hui, M.; Ng, D.K.P.; Lo, P.-C. Oligolysine-Conjugated Zinc(II) Phthalocyanines as Efficient Photosensitizers for Antimicrobial Photodynamic Therapy. Chem. Asian J. 2014, 9, 1868–1875. [Google Scholar] [CrossRef] [PubMed]
- Mantareva, V.; Gol, C.; Kussovski, V.; Durmuş, M.; Ivan Angelov, I. Impact of water-soluble zwitterionic Zn(II) phthalocyanines against pathogenic bacteria. Z. Naturforsch. 2019, 74, 183–191. [Google Scholar] [CrossRef] [PubMed]
- Mantareva, V.; Kussovski, V.; Durmuş, M.; Borisova, E.; Angelov, I. Photodynamic inactivation of pathogenic species Pseudomonas aeruginosa and Candida albicans with lutetium (III) acetate phthalocyanines and specific light irradiation. Lasers Med. Sci. 2016, 31, 1591–1598. [Google Scholar] [CrossRef]
- Ömeroğlu, I.; Kaya, E.N.; Göksel, M.; Kussovski, V.; Mantareva, V.; Durmuş, M. Axially substituted silicon(IV) phthalocyanine and its quaternized derivative as photosensitizers towards tumor cells and bacterial pathogens. Bioorg. Med. Chem. 2017, 25, 5415–5422. [Google Scholar] [CrossRef]
- Nyamu, S.N.; Ombaka, L.; Masika, E.; Ng’ang’a, M. Antimicrobial Photodynamic Activity of Phthalocyanine Derivatives. Adv. Chem. 2018, 2018, 2598062. [Google Scholar] [CrossRef]
- Meerovich, G.A.; Akhlyustina, E.V.; Tiganova, I.G.; Lukyanets, E.A.; Makarova, E.A.; Tolordava, E.R.; Yuzhakova, O.A.; Romanishkin, I.D.; Philipova, N.I.; Zhizhimova, Y.S.; et al. Photodynamic inactivation of Pseudomonas aeruginosa bacterial biofilms using new polycationic photosensitizers. Laser Phys. Lett. 2019, 16, 115603. [Google Scholar] [CrossRef]
- Pucelik, B.; Paczyński, R.; Dubin, G.; Pereira, M.M.; Arnaut, L.G.; Dąbrowski, J.M. Properties of halogenated and sulfonated porphyrins relevant for the selection of photosensitizers in anticancer and antimicrobial therapies. PLoS ONE 2017, 12, e0185984. [Google Scholar] [CrossRef]
- Hamblin, M.R.; Hasan, T. Photodynamic therapy: A new antimicrobial approach to infectious disease? Photochem. Photobiol. Sci. 2004, 3, 436–450. [Google Scholar] [CrossRef] [Green Version]
- Denyer, S.P.; Maillard, J.-Y. Cellular impermeability and uptake of biocides and antibiotics in Gram-negative bacteria. J. Appl. Microbiol. 2002, 92, 35–45. [Google Scholar] [CrossRef]
- Nikaido, H. Molecular Basis of Bacterial Outer Membrane Permeability Revisited. Microbiol. Mol. Biol. Rev. 2003, 67, 593–656. [Google Scholar] [CrossRef] [Green Version]
- Długaszewska, J.; Antczak, M.; Kaczmarek, I.; Jankowiak, R.; Buszkiewicz, M.; Herkowiak, M.; Michalak, K.; Kukuła, H.; Ratajczak, M. In vitro biofilm formation and antibiotic susceptibility of Pseudomonas aeruginosa isolated from airways of patients with cystic fibrosis. J. Med. Sci. 2016, 85, 245–253. [Google Scholar] [CrossRef]
- George, S.; Hamblin, M.R.; Kishen, A. Uptake pathways of anionic and cationic photosensitizers into bacteria. Photochem. Photobiol. Sci. 2009, 8, 788–795. [Google Scholar] [CrossRef] [PubMed] [Green Version]
- Ratajczak, M.; Kamińska, D.; Nowak-Malczewska, D.M.; Anna Schneider, A.; Dlugaszewska, J. Relationship between antibiotic resistance, biofilm formation, genes coding virulence factors and source of origin of Pseudomonas aeruginosa clinical strains. Ann. Agric. Environ. Med. 2021, 28, 306–313. [Google Scholar] [CrossRef] [PubMed]

| Strain No. | Source of Isolation | Resistance to Antibiotics | MBL | Biofilm Formation | |||||
|---|---|---|---|---|---|---|---|---|---|
| PRL | CAZ | IPM | MEM | CIP | TOB | ||||
| 1 | L. resp. tract | S | S | R | R | S | S | - | S |
| 10 | L. resp. tract | S | S | R | R | S | S | - | M |
| 16 | L. resp. tract | S | S | S | S | S | S | - | S |
| 21 | L. resp. tract | S | S | R | R | R | R | - | S |
| 22 | L. resp. tract | S | S | R | R | S | S | - | S |
| 23 | L. resp. tract | S | S | S | S | S | S | - | W |
| 36 | L. resp. tract | R | R | R | R | R | S | + | S |
| 50 | L. resp. tract | R | R | R | R | R | S | + | S |
| 52 | L. resp. tract | S | S | S | R | S | S | - | S |
| 62 | L. resp. tract | R | R | R | R | R | S | + | S |
| 68 | L. resp. tract | S | S | S | R | S | S | - | S |
| 69 | L. resp. tract | S | S | R | R | S | S | - | M |
| 75 | L. resp. tract | S | S | S | S | R | S | - | S |
| 3 | chronic wound | S | S | S | S | S | S | - | S |
| 5 | chronic wound | S | S | S | S | S | S | - | W |
| 6 | chronic wound | S | S | S | I | S | S | - | M |
| 30 | chronic wound | S | S | S | S | S | S | - | S |
| 35 | chronic wound | S | S | S | S | S | S | - | M |
| 67 | chronic wound | S | S | R | R | I | S | - | W |
| 73 | chronic wound | S | S | S | R | S | S | - | M |
| 33 | chronic wound | R | R | R | R | R | R | + | S |
| 34 | chronic wound | R | S | S | S | S | S | - | S |
| 38 | chronic wound | R | R | R | R | R | R | + | S |
| 40 | chronic wound | S | S | R | R | S | S | - | S |
| 42 | chronic wound | S | S | I | S | S | S | - | S |
| 46 | chronic wound | S | S | S | R | S | S | - | S |
| 49 | chronic wound | R | R | R | R | R | S | + | S |
| 45 | chronic wound | S | S | R | R | S | S | - | S |
| 72 | chronic wound | S | S | S | I | S | S | - | S |
Publisher’s Note: MDPI stays neutral with regard to jurisdictional claims in published maps and institutional affiliations. |
© 2022 by the authors. Licensee MDPI, Basel, Switzerland. This article is an open access article distributed under the terms and conditions of the Creative Commons Attribution (CC BY) license (https://creativecommons.org/licenses/by/4.0/).
Share and Cite
Szczolko, W.; Ratajczak, M.; Koczorowski, T.; Kaminska, D.; Goslinski, T.; Dlugaszewska, J. Promising Photocytotoxicity of Water-Soluble Phtalocyanine against Planktonic and Biofilm Pseudomonas aeruginosa Isolates from Lower Respiratory Tract and Chronic Wounds. Appl. Sci. 2022, 12, 3707. https://doi.org/10.3390/app12083707
Szczolko W, Ratajczak M, Koczorowski T, Kaminska D, Goslinski T, Dlugaszewska J. Promising Photocytotoxicity of Water-Soluble Phtalocyanine against Planktonic and Biofilm Pseudomonas aeruginosa Isolates from Lower Respiratory Tract and Chronic Wounds. Applied Sciences. 2022; 12(8):3707. https://doi.org/10.3390/app12083707
Chicago/Turabian StyleSzczolko, Wojciech, Magdalena Ratajczak, Tomasz Koczorowski, Dorota Kaminska, Tomasz Goslinski, and Jolanta Dlugaszewska. 2022. "Promising Photocytotoxicity of Water-Soluble Phtalocyanine against Planktonic and Biofilm Pseudomonas aeruginosa Isolates from Lower Respiratory Tract and Chronic Wounds" Applied Sciences 12, no. 8: 3707. https://doi.org/10.3390/app12083707
APA StyleSzczolko, W., Ratajczak, M., Koczorowski, T., Kaminska, D., Goslinski, T., & Dlugaszewska, J. (2022). Promising Photocytotoxicity of Water-Soluble Phtalocyanine against Planktonic and Biofilm Pseudomonas aeruginosa Isolates from Lower Respiratory Tract and Chronic Wounds. Applied Sciences, 12(8), 3707. https://doi.org/10.3390/app12083707

